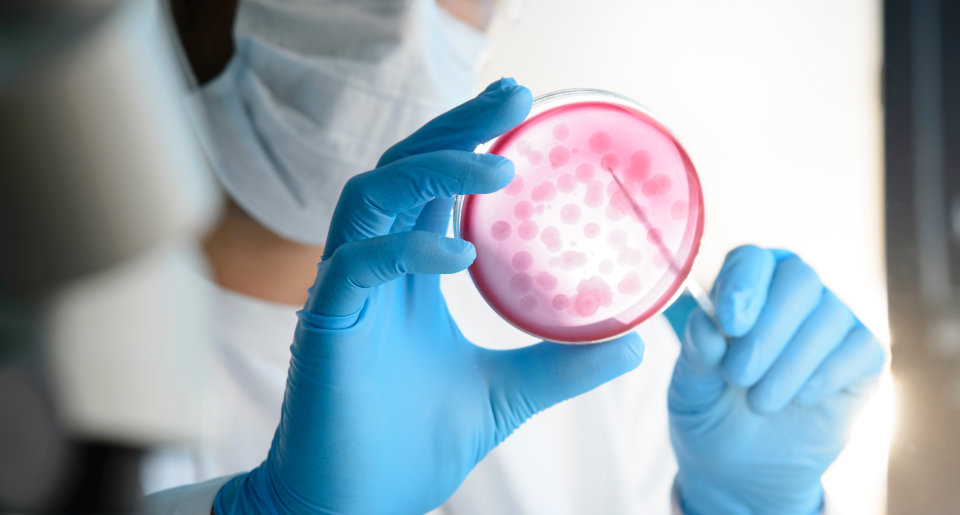

あなたのありたい世界に変えていくこと
当社は、「美容医学」、「細胞再生」、「予防医療」、「病気の治療」の4つの分野の製品を提供しており、各分野に関連する医療機器の小売販売も行っています。また、産業界と学界間の提携に基づいたコア・コンピタンスを形成してきました。これによって、医師が臨床データおよび科学的データに基づいて、安全かつ効果的な製品を確実に受け取れるようにできることが可能になります。

事業活動
当社は、主に流通と自社ブランドの開発を通じて、医師にサービスを提供していくバイオ医薬品企業です。また、世界中の医療、健康、福祉製品などの関連職種に携わる医療専門家や医師にサービスを提供していくことを目的としています。

学術活動
当社は医療機関と協力し、新薬研究データの提供や、SCIMedicalJournalsの発行、さらに医療分野研究の国際シンポジウムにも積極的に参加してきました。
当社の強み
私たちのビジョンとして、人々の活力と生活の質を維持しながら、老化のプロセスをガイドラインを創造していくことです。
使命として、人々の生活をより良くする製品を追求し、提供することです。
クライアントが期待する以上のサビースを提供し、クライアントと長期的な信頼関係を構築し、クライアントのニーズを理解・共感・問題解決することです。
1.市場でユニークかつ高品質で革新的な製品を提供していきます。
2.医師のスキル向上とのサポートをし、医療分野での知識を拡大していきます。
3.患者との信頼を確立するために、医師の評価を高めていくことを目指します。
ドラッグデリバリーシステム(DDS)
DDSとは、事業開発プロジェクトで使用されている薬物輸送システム(特許取得済み)のことを指します。これには、特許取得済みのNDS皮膚浸透システムないし、水溶性・透過性・吸収性エンハンサーなど適応性の高い低分子を輸送する性質を持っています。これは主に製品の皮膚伝達に使用され、局所的な皮膚の症状の改善や初回通過効果を回避することができます。また、安全に使用が可能であることから、皮膚から製品の適切な浸透を実現することができます。


皮膚研究センター
間葉系幹細胞とは、皮膚細胞や血管細胞など、さまざまな成体細胞に変化できる原始細胞を指します。当社では間葉系幹細胞製品の開発のために火傷や熱傷の治療に臨床経験と技術を導入してきました。これらの製品は、皮膚の老化防止というニーズを満たすために皮膚のケラチノサイトを刺激する成分を含みます。
